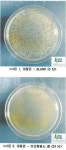
다원바이오텍, 친환경 살균·탈취제 디오투 개발

주식회사 디오에이치바이오 총101명이 열람하였으며, 0개의 리뷰가 있습니다.
- 번호
- 37,615
- 개방서비스명
- 의료기기판매(임대)업
- 개방서비스아이디
- 01_02_03_P
- 개방자치단체코드
- 3,190,000
- 관리번호
- PHMG120233190033047000023
- 인허가일자
- 2023-02-21
- 영업상태구분코드
- 1
- 영업상태명
- 영업/정상
- 상세영업상태코드
- 13
- 상세영업상태명
- 영업중
- 소재지전체주소
- 서울특별시 동작구 노량진동 ***-*
- 도로명전체주소
- 서울특별시 동작구 노량진로*길 **, *층 *호 (노량진동)
- 도로명우편번호
- 6,930
- 사업장명
- 주식회사 디오에이치바이오
- 최종수정시점
- 2023-02-22 10:03:27
- 데이터갱신구분
- I
- 데이터갱신일자
- 2023-02-24 00:41:03
- 좌표정보x(epsg5174)
- 127
- 좌표정보y(epsg5174)
- 38
- 총규모
- 147
주변 목록 (8)
국민건강관리원
서울특별시 동작구 노량진동 ***-*
'주식회사 디오에이치바이오'에서 0km
서울특별시 동작구 노량진동 ***-*
바로가기
(주)코리아세븐 노량제일점
서울특별시 동작구 노량진동 **-**
'주식회사 디오에이치바이오'에서 0.1km
서울특별시 동작구 노량진동 **-**
바로가기
지에스25 노량진본점
서울특별시 동작구 노량진동 ***-**
'주식회사 디오에이치바이오'에서 0.1km
서울특별시 동작구 노량진동 ***-**
바로가기
이마트24 노량진중앙점
서울특별시 동작구 노량진동 **-*
'주식회사 디오에이치바이오'에서 0.2km
서울특별시 동작구 노량진동 **-*
바로가기
지에스25노량진수산시장점
서울특별시 동작구 노량진동 *** 노량진 수산물 도매시장 *층 편의점호
'주식회사 디오에이치바이오'에서 0.3km
서울특별시 동작구 노량진동 *** 노량진 수산물 도매시장 *층 편의점호
바로가기
(주)유한양행
서울특별시 동작구 대방동 **번지 *호 (주)유한양행
'주식회사 디오에이치바이오'에서 0.3km
서울특별시 동작구 대방동 **번지 *호 (주)유한양행
바로가기
지에스25노량아이비
서울특별시 동작구 노량진동 **-* 노량진아이비빌딩
'주식회사 디오에이치바이오'에서 0.3km
서울특별시 동작구 노량진동 **-* 노량진아이비빌딩
바로가기
씨유 노량진 드림스퀘어점
서울특별시 동작구 노량진동 **-* 노량진 드림스퀘어 복합빌딩
'주식회사 디오에이치바이오'에서 0.3km
서울특별시 동작구 노량진동 **-* 노량진 드림스퀘어 복합빌딩
바로가기
주변 의료기기 수리업 (12)
지체장애인지원센터
서울특별시 동작구 대방동 23-166
'주식회사 디오에이치바이오'에서 0.33km
바로가기
(주)가남교역
서울특별시 영등포구 여의도동 43번지 미원빌딩 608호
'주식회사 디오에이치바이오'에서 1.11km
바로가기
제이엘메드(주)
서울특별시 동작구 상도2동 204번지 69호 주은빌딩 1층
'주식회사 디오에이치바이오'에서 1.28km
바로가기
소닉헬스케어 주식회사
서울특별시 동작구 본동 494 래미안 트윈파크
'주식회사 디오에이치바이오'에서 1.28km
바로가기
소닉메디케어 주식회사
서울특별시 동작구 본동 494 래미안 트윈파크
'주식회사 디오에이치바이오'에서 1.28km
바로가기
알파케어
서울특별시 동작구 상도동 154번지 5호 백산
'주식회사 디오에이치바이오'에서 1.28km
바로가기
(주)클라헬스케어
서울특별시 영등포구 신길동 92-18
'주식회사 디오에이치바이오'에서 1.49km
바로가기
솔케어
서울특별시 영등포구 신길동 459-5 신길프라자
'주식회사 디오에이치바이오'에서 1.51km
바로가기
㈜유비케어
서울특별시 영등포구 여의도동 22 파크원
'주식회사 디오에이치바이오'에서 1.66km
바로가기
일루미나코리아 유한회사
서울특별시 영등포구 여의도동 23-3 하이투자증권
'주식회사 디오에이치바이오'에서 1.73km
바로가기
(주)프레제니우스메디칼케어코리아
서울특별시 영등포구 여의도동 28-1 에프케이아이타워
'주식회사 디오에이치바이오'에서 1.78km
바로가기
덕우메디칼솔루션
서울특별시 영등포구 신길동 192-79
'주식회사 디오에이치바이오'에서 2.13km
바로가기
주변 부속 의료기관 (12)
한화생명보험(주)본사 부속의원
서울특별시 영등포구 여의도동 60번지 지하2층
'주식회사 디오에이치바이오'에서 0.87km
바로가기
국민은행 본점 부속의원
서울특별시 영등포구 여의도동 45 KB국민은행 신관
'주식회사 디오에이치바이오'에서 1.11km
바로가기
엘지에너지솔루션부속의원
서울특별시 영등포구 여의도동 22 파크원
'주식회사 디오에이치바이오'에서 1.66km
바로가기
금융감독원부속치과의원
'주식회사 디오에이치바이오'에서 1.77km
바로가기
병무청중앙신체검사소
서울특별시 영등포구 신길동 산 159번지 1호
'주식회사 디오에이치바이오'에서 1.79km
바로가기
서울지방병무청
서울특별시 영등포구 신길동 산 159번지 1호
'주식회사 디오에이치바이오'에서 1.79km
바로가기
엘지트윈부속의원
서울특별시 영등포구 여의도동 20
'주식회사 디오에이치바이오'에서 1.82km
바로가기
한국산업은행부속치과의원
서울특별시 영등포구 여의도동 16번지 8층
'주식회사 디오에이치바이오'에서 2.11km
바로가기
한국수출입은행부속치과의원
서울특별시 영등포구 여의도동 16번지 1호
'주식회사 디오에이치바이오'에서 2.12km
바로가기
영등포보현의집 부속의원
서울특별시 영등포구 영등포동2가 94번지 31호 1층
'주식회사 디오에이치바이오'에서 2.31km
바로가기
국회사무처부속한의원
서울특별시 영등포구 여의도동 1 국회
'주식회사 디오에이치바이오'에서 2.77km
바로가기
국회사무처부속치과의원
'주식회사 디오에이치바이오'에서 2.77km
바로가기
주변 의료 유사업 (12)
동작약손지압안마원
서울특별시 동작구 노량진동 41번지 5호 307호
'주식회사 디오에이치바이오'에서 0.15km
바로가기
참손길지압안마원
서울특별시 영등포구 여의도동 44-37 아일렉스타워
'주식회사 디오에이치바이오'에서 0.87km
바로가기
씨에프(CF)안마시술소
서울특별시 영등포구 여의도동 44번지 32호 4,5층
'주식회사 디오에이치바이오'에서 0.97km
바로가기
한강안마원
서울특별시 동작구 노량진1동 194번지 3호 3층 301호
'주식회사 디오에이치바이오'에서 1.07km
바로가기
튼튼안마원
서울특별시 동작구 상도동 347-4 인터비젼빌딩
'주식회사 디오에이치바이오'에서 1.3km
바로가기
손박사지압안마원
서울특별시 영등포구 신길동 832번지
'주식회사 디오에이치바이오'에서 1.56km
바로가기
보라매지압원
서울특별시 동작구 대방동 395-15 하이빌
'주식회사 디오에이치바이오'에서 1.66km
바로가기
학예안마원
서울특별시 동작구 신대방동 724 보라매자이 더 포레스트 상가동 1431호
'주식회사 디오에이치바이오'에서 1.81km
바로가기
힐링지압안마원
서울특별시 동작구 대방동 417번지 2호 3층
'주식회사 디오에이치바이오'에서 2.05km
바로가기
보라매안마원
서울특별시 관악구 보라매동 972번지 21호 2층
'주식회사 디오에이치바이오'에서 2.65km
바로가기
스마일안마원
서울특별시 영등포구 영등포동3가 20-6
'주식회사 디오에이치바이오'에서 2.66km
바로가기
드림안마시술소
서울특별시 영등포구 영등포동 423번지 44호
'주식회사 디오에이치바이오'에서 2.76km
바로가기
주변 의료법인 (12)
의료법인 성석의료재단
서울특별시 동작구 상도동 188번지 19호
'주식회사 디오에이치바이오'에서 1.12km
바로가기
성애의료재단
서울특별시 영등포구 신길동 451번지 2호 성애병원
'주식회사 디오에이치바이오'에서 1.21km
바로가기
의료법인 건양의료재단
서울특별시 영등포구 영등포동4가 123번지 2호
'주식회사 디오에이치바이오'에서 3.19km
바로가기
의료법인 마티아의료재단
서울특별시 영등포구 대림동 603번지 26호 코스모메디칼
'주식회사 디오에이치바이오'에서 3.54km
바로가기
의료법인 춘혜의료재단
서울특별시 영등포구 대림3동 782번지 3호
'주식회사 디오에이치바이오'에서 3.72km
바로가기
에이치엠피의료재단
서울특별시 동작구 신대방동 686번지 1호
'주식회사 디오에이치바이오'에서 3.76km
바로가기
의료법인 창덕의료재단
서울특별시 영등포구 당산동2가 4번지 3호
'주식회사 디오에이치바이오'에서 3.76km
바로가기
의료법인 인봉의료재단
서울특별시 영등포구 당산동3가 386번지 3호 영등포병원
'주식회사 디오에이치바이오'에서 3.92km
바로가기
의료법인 서울효천의료재단
서울특별시 관악구 신림동 10-715 양지병원
'주식회사 디오에이치바이오'에서 4.11km
바로가기
사단법인 한국노동협회
서울특별시 용산구 갈월동 85번지 3호 남영빌딩206호
'주식회사 디오에이치바이오'에서 4.72km
바로가기
의료법인 우리아이들 의료재단
서울특별시 구로구 구로동 586번지 5호
'주식회사 디오에이치바이오'에서 4.9km
바로가기
학교법인고려중앙학원
서울특별시 구로구 구로동 80번지
'주식회사 디오에이치바이오'에서 5.1km
바로가기
주변 병원 (12)
가톨릭대학교 여의도성모병원
'주식회사 디오에이치바이오'에서 0.61km
바로가기
청화병원
서울특별시 동작구 노량진동 311번지 8호 외 4필지
'주식회사 디오에이치바이오'에서 0.69km
바로가기
성애의료재단 성애병원
'주식회사 디오에이치바이오'에서 1.21km
바로가기
어울림병원
서울특별시 영등포구 신길동 65번지 33호
'주식회사 디오에이치바이오'에서 1.36km
바로가기
정동병원
서울특별시 동작구 상도1동 614번지 1호
'주식회사 디오에이치바이오'에서 1.43km
바로가기
연세베스트요양병원
서울특별시 영등포구 신길동 861번지 일이빌딩
'주식회사 디오에이치바이오'에서 1.51km
바로가기
연세제일요양병원
서울특별시 동작구 상도동 255번지 4호
'주식회사 디오에이치바이오'에서 1.53km
바로가기
대윤한방병원
'주식회사 디오에이치바이오'에서 1.65km
바로가기
기분좋은한방병원
서울특별시 동작구 신대방동 358-3
'주식회사 디오에이치바이오'에서 1.92km
바로가기
서울바른병원
서울특별시 영등포구 신길동 505번지 2층~7층
'주식회사 디오에이치바이오'에서 1.99km
바로가기
중앙대학교병원
서울특별시 동작구 흑석동 224번지 1호
'주식회사 디오에이치바이오'에서 2.24km
바로가기
재단법인한국산업보건환경연구소부설 해상병원
'주식회사 디오에이치바이오'에서 2.34km
바로가기
블로그 리뷰
-
우리비 주식회사 인천광역시 부평구 삼산동 426-6번지 선우프라자 602호 23047 우리비오텍(주)... 우양에이치앤비 서울특별시 영등포구 여의도동 43-3번지 홍우빌딩1004호 23135...
리치캣의 현재 그리고 미래(20221019)

-
중앙로역 )전주식당 ](중구대흥동 )서울식당’와 GUDORO &, 용두동의 CNC와 (중구 계룡로881번길 30, 용두동 14-13)샘골식당와 (선화로22번길 18 102호, 용두동 26-15)팔도청국장갓솥‘대전본점 /, >>대사동...
전화통화 신분확인.말을못해서 말을하지않는게아니다(20260603)

-
중앙로역 )전주식당 ](중구대흥동 )서울식당’와 GUDORO &, 용두동의 CNC와 (중구 계룡로881번길 30, 용두동 14-13)샘골식당와 (선화로22번길 18 102호, 용두동 26-15)팔도청국장갓솥‘대전본점 /, >>대사동...
전화통화 신분확인.말을못해서 말을하지않는게아니다(20260607)

-
중앙로역 )전주식당 ](중구대흥동 )서울식당’와 GUDORO &, 용두동의 CNC와 (중구 계룡로881번길 30, 용두동 14-13)샘골식당와 (선화로22번길 18 102호, 용두동 26-15)팔도청국장갓솥‘대전본점 /, >>대사동...
전화통화 신분확인.말을못해서 말을하지않는게아니다(20260607)

-
중앙로역 )전주식당 ](중구대흥동 )서울식당’와 GUDORO &, 용두동의 CNC와 (중구 계룡로881번길 30, 용두동 14-13)샘골식당와 (선화로22번길 18 102호, 용두동 26-15)팔도청국장갓솥‘대전본점 /, >>대사동...
전화통화 신분확인.말을못해서 말을하지않는게아니다(20260603)

-
tech) 바이오탑 (Bio Top) 강원옵틱 유즈테크(YUZU TECH) 주)프라임텍 주식회사 티앤아이 에이치바이오(Hbio)... 유한회사 바이오드림 주식회사 케이엘사이언스 에이비진(Abgene) 엠이비 제이비사이언스 주식회사...
✨️헬시 푸드러버(20260602)

-
건전화목적으로 에이치원래디오(주) 주식 847,500주를 131.99억원에 처분하기로 결정... 더바이오메드(214610) - 롤링스톤 주식회사로 상호변경 예정 * 레이저쎌(412350) - 운영자금 등 확보...
박학다식(20250919)

-
시화치과 바이오모아메디칼 주식회사, 농업회사법인서정 유한회사 승우엔지니어링... 비트윈스페이스 주식회사 한미글로벌피엠씨건축사사무소, (주)스페이스닷온 주식회사에이치팩(HPACKCo.,Ltd.), 라하프케어...
세금은 홈택스 차량은 카택스(20250212)

-
상진 디오 The-O 스툴과 싸이클 운동 기구의 조화로움이 돋보이는 운동 가구에요. 인테리어와 실용성을 겸비한 운동기구라니! 정말 독특했어요. LG전자 주식회사 LG 퓨리케어 오브제컬렉션 에어로퍼니처...
쎄려니(20231102)

-
자기주식 35만 7296주 소각 결정 8. 호전실업 - 자회사 대용무역에 272억 7780만 원 규모 채무보증 결정 9. 일진홀딩스 - 특수목적법인 사이닝제일차 주식회사에...
소박대박(20260519)

일별 방문 통계
월별 방문 통계
카카오맵 바로가기
카카오맵 위치 기준 길안내
리뷰 (0)
등록된 리뷰가 없습니다.
관련 지도 선택 및 번역
첨부파일

![[BIOMAX] Happy Cells + (실험실 오염방지) : 에이치바이오주식회사](https://search.pstatic.net/common/?type=b150&src=http%3A%2F%2Fshop1.phinf.naver.net%2F20250415_233%2F1744698940333Ahqpp_PNG%2F682625475244849_1474350240.png)

![[BIOMAX] OxiTec SOD Assay Kit (Colorimetric) : 에이치바이오주식회사](https://search.pstatic.net/common/?type=b150&src=http%3A%2F%2Fshop1.phinf.naver.net%2F20250415_110%2F1744702966740ElLNd_PNG%2F78835813878786268_1406631613.png)
![[랩테크]고압멸균기 오토클레이브 연구실 소독 살균 Autoclave : 에이치바이오주식회사](https://search.pstatic.net/common/?type=b150&src=http%3A%2F%2Fshop1.phinf.naver.net%2F20230831_190%2F1693448675587g4o7p_JPEG%2F43524212961999574_917548405.jpg)
![[인더스트리얼 리뷰]주식회사 레고켐 바이오사이언스](https://search.pstatic.net/common/?type=b150&src=http%3A%2F%2Fimgnews.naver.net%2Fimage%2F020%2F2011%2F12%2F01%2F42259491.1.jpg)
![[랩테크]Forced Convection Oven 강제순환 건조기-경제형 LDO-080F/LDO-150F/LDO-250F : 에이치바이오주식회사](https://search.pstatic.net/common/?type=b150&src=http%3A%2F%2Fshop1.phinf.naver.net%2F20240404_114%2F1712196431519Fzh8p_PNG%2F113332327254383883_29128586.png)
![[랩테크]Multi Chamber Water Bath 워터베스 LWB-211D/LWB-311D/LWB-311DS/LID-311D : 에이치바이오주식회사](https://search.pstatic.net/common/?type=b150&src=http%3A%2F%2Fshop1.phinf.naver.net%2F20240404_105%2F1712213810465zG2P1_PNG%2F113349699174030485_1780403730.png)
![[랩테크]클린벤치 무균작업대 흄후드 LCB-901V LCB-1201V LCB-1501V LCB-1801V : 에이치바이오주식회사](https://search.pstatic.net/common/?type=b150&src=http%3A%2F%2Fshop1.phinf.naver.net%2F20230831_30%2F1693444693754TMf1j_JPEG%2F39284730574174257_1170043993.jpg)
